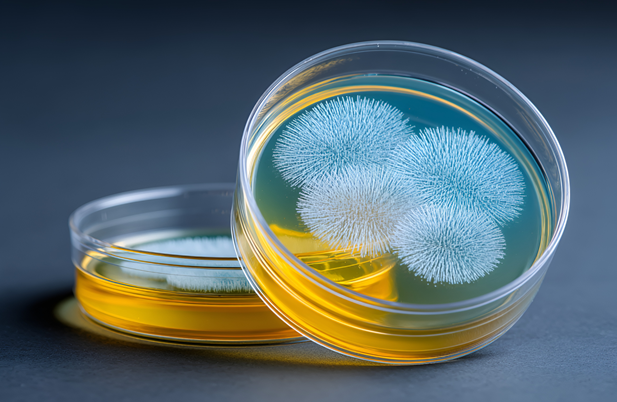
11.png

Chinese Researchers Reveal Mechanisms of Aflatoxin Diversity, Aiding Precision Control
On March 18, a significant research finding by a team from the Oil Crops Research Institute of the Chinese Academy of Agricultural Sciences was published online in the international academic journal Nature Communications. The study systematically uncovers the mechanisms driving the phylogenetic geographic differentiation and metabolic diversity of Aspergillus flavus, providing a crucial theoretical basis for predicting aflatoxin contamination risks and implementing precise prevention and control measures.
Aflatoxins, mainly produced by fungi such as Aspergillus flavus, pose severe threats to food security and public health due to their carcinogenic, teratogenic, mutagenic, immunosuppressive and hepatotoxic properties, and are closely associated with the occurrence of liver cancer. These toxins contaminate more than 110 types of foods and raw materials, including agricultural products such as peanuts, corn and rice.
With the intensification of global climate change in recent years, the distribution range of Aspergillus flavus has continued to expand, leading to a rising risk of toxin contamination. However, the significant differences in toxin-producing capacity among Aspergillus flavus strains from different regions have long lacked systematic understanding, hindering the precise prediction and effective control of aflatoxin contamination.
To address this gap, the research team integrated 1,052 Aspergillus flavus strains from four continents worldwide, establishing the world’s largest multi-omics dataset for Aspergillus flavus. Through phylogenetic, genomics, metabolomics and environmental association analyses, the team made key discoveries.
The study found that the toxin-producing capacity of Aspergillus flavus strains is closely linked to genetic differentiation, with obvious geographic differentiation in the phylogenetic characteristics of Aspergillus flavus populations. High-toxin-producing strains are mainly concentrated in low-latitude regions with high temperature and humidity.
Notably, the differences in toxin-producing capacity among strains are not primarily determined by biosynthetic gene clusters, but are dominated by regulatory gene variations and primary metabolic pathway reprogramming. Environmental factors such as temperature, humidity and soil properties drive the evolution of metabolic phenotypes by selecting key regulatory pathways, thereby influencing the toxin-producing capacity of strains.
The research also revealed that some low-toxin-producing subpopulations can produce other types of mycotoxins, indicating potential risks in traditional biocontrol strategies based on non-toxin-producing strains. This breakthrough deepens the understanding of fungal environmental adaptation and metabolic evolution, and provides key theoretical support for developing widely applicable precise control technologies tailored to regional environmental characteristics, which is of great significance for safeguarding food and food safety.
